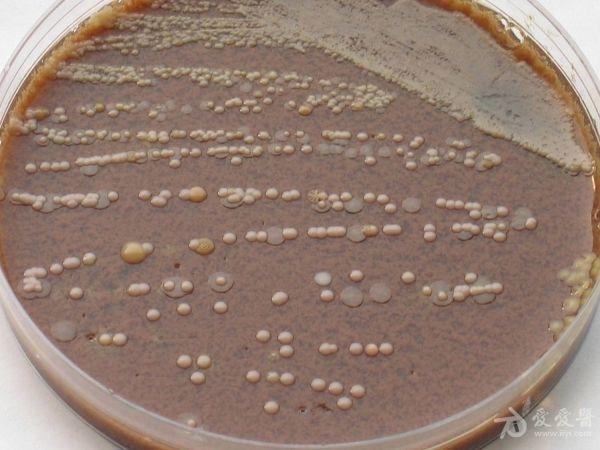
卡他莫拉菌的分离与鉴定

卡他球菌

奈瑟卡他球菌肺炎
图片尺寸500x405
卡塔旗舰店卡他球菌2022已更新今日动态
图片尺寸474x355
卡他莫拉菌的分离与鉴定
图片尺寸600x450
(一)卡他莫拉菌
图片尺寸960x540
金黄色葡萄球菌,a群链球菌等;常见革兰阴性细菌包括:流感嗜血杆菌,卡
图片尺寸1000x702
卡他莫拉菌的分离与鉴定
图片尺寸1025x769
儿童急性中耳炎的病因治疗主要是抗菌药物的应用,结合其他对症治疗等
图片尺寸691x510
专家看检引起肺部感染的除了新冠病毒它也是主力
图片尺寸1080x395
奈瑟卡他球菌肺炎
图片尺寸221x168
婀娜多姿的细菌第二部分抗生素作用下细菌的模样
图片尺寸600x658
2 卡他莫拉菌(头孢曲松 敏感):与正常菌体相比,细菌大小不一,有些菌体
图片尺寸600x660
健闻登顶计划
图片尺寸690x594
卡他莫拉菌
图片尺寸220x165
这属于过度包装吗
图片尺寸1080x1439
克拉维酸与替卡西林联合可抑制大肠杆菌,流感嗜血杆菌,卡他球菌,克雷
图片尺寸200x154
家里老人要吃的药,他觉得药店买太贵了,问我能不能网上买,我找不到
图片尺寸1080x1439
呜呜呜刀片嗓吃头孢有没有用
图片尺寸1080x608
1~2:1),氨苄西林——舒巴坦(2:1),主要针对流感嗜血杆菌,肺炎球菌,卡
图片尺寸1024x768
卡他莫拉菌引起的肺炎脑细菌感染,说明肺炎球菌
图片尺寸800x533
c :葡萄球菌,链球菌,肺炎链球菌 g - c :脑膜炎奈瑟菌,淋病奈瑟菌,卡
图片尺寸730x410